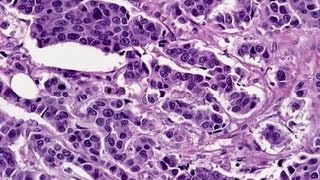

Medical School Pathology 2012 Session 075 Graduation Day 2012.mp4 video
Online izle ve mp4 mp3 formatlarinda yukle

Videonun muddeti: 1:38:33
Medical School Pathology 2012 Session 075 Graduation Day 2012.mp4 videosu mp4 ve mp3 yuklemek ucun hazirdir
Diqqet! Siz Mp4 yukle ve ya Mp3 yukle duymesine basdiqdan sonra eger sistem sizi reklam sehifesine atarsa o zaman derhal geri qayidib emeliyyati tekrar edin ve faylin yuklemek ucun hazir olmasini gozleyin
Videodan Mp4 Yukle
Videodan Mp3 Yukle-1
Videodan Mp3 Yukle-2
Oxshar Axtarishlar
 Medical School Pathology 2012 Session 075 Graduation Day 2012.mp4
Medical School Pathology 2012 Session 075 Graduation Day 2012.mp4 Medical School Pathology 2012 Session 076 Eye.mp4
Medical School Pathology 2012 Session 076 Eye.mp4 Medical School Pathology 2012 Session 047 WBC Lab.mp4
Medical School Pathology 2012 Session 047 WBC Lab.mp4 Medical School Pathology 2012 Session 073 Ortho II.mp4
Medical School Pathology 2012 Session 073 Ortho II.mp4 Medical School Pathology 2012 Session 074 Nerve-Muscle.mp4
Medical School Pathology 2012 Session 074 Nerve-Muscle.mp4 Medical School Pathology 2012 Session 012 Neoplasms II.mp4
Medical School Pathology 2012 Session 012 Neoplasms II.mp4 Medical School Pathology 2012 Session 040 Blood Vessels III and Lab.mp4
Medical School Pathology 2012 Session 040 Blood Vessels III and Lab.mp4 Harvard Medical School Graduation Ceremony Class of 2024 #harvard #harvarduniversity
Harvard Medical School Graduation Ceremony Class of 2024 #harvard #harvarduniversity Medical School Pathology 2012 Session 046 WBC III.mp4
Medical School Pathology 2012 Session 046 WBC III.mp4
Video Mp4 Mp3Azwap.Biz
Azwap.Biz 2021-2023


 Medical School Pathology 2012 Session 075 Graduation Day 2012.mp4
Medical School Pathology 2012 Session 075 Graduation Day 2012.mp4 Medical School Pathology 2012 Session 076 Eye.mp4
Medical School Pathology 2012 Session 076 Eye.mp4 Medical School Pathology 2012 Session 047 WBC Lab.mp4
Medical School Pathology 2012 Session 047 WBC Lab.mp4 Medical School Pathology 2012 Session 073 Ortho II.mp4
Medical School Pathology 2012 Session 073 Ortho II.mp4 Medical School Pathology 2012 Session 074 Nerve-Muscle.mp4
Medical School Pathology 2012 Session 074 Nerve-Muscle.mp4 Medical School Pathology 2012 Session 012 Neoplasms II.mp4
Medical School Pathology 2012 Session 012 Neoplasms II.mp4 Medical School Pathology 2012 Session 040 Blood Vessels III and Lab.mp4
Medical School Pathology 2012 Session 040 Blood Vessels III and Lab.mp4 Harvard Medical School Graduation Ceremony Class of 2024 #harvard #harvarduniversity
Harvard Medical School Graduation Ceremony Class of 2024 #harvard #harvarduniversity Medical School Pathology 2012 Session 046 WBC III.mp4
Medical School Pathology 2012 Session 046 WBC III.mp4